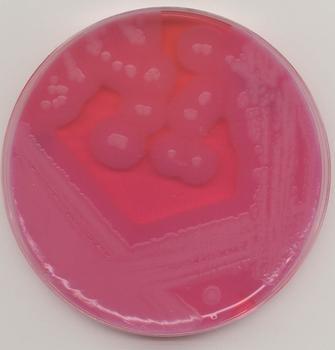
新生霉素溶液特价供应

产品分类
- 抑制剂 (9654)
- 试剂 (2806)
- elisa试剂盒 (2913)
- ATCC细胞 (1367)
- 标准品 (662)
- 培养基 (978)
- USP标准品 (1816)
- ELISA检测试剂盒 (7004)
- 抗体 (4434)
- 标准品、对照品 (1873)
- RNA/DNA提取 (1134)
- ELISA Kit (3185)
- 原代细胞 (297)
- 标准品 (348)
- PCR检测试剂盒 (1300)
- 德国DRG试剂盒 (304)
- 生命科学 (672)
- 生化检测试剂盒 (452)
- 标准物质 (1116)
- 生化试剂 (2130)
- 进口品牌 (221)
- 代理品牌 (27)
- 生物碱 (500)
- 黄酮 (537)
- 查尔酮 (51)
- 氧杂蒽酮 (182)
- 香豆素 (171)
- 木脂素 (68)
- 苯丙素 (96)
- 药物杂质及中间体 (830)
- 其它天然产物 (154)
- 蒽醌 (27)
- 其它醌类 (46)
- 甾体 (166)
- 二萜 (508)
- 其它萜类 (57)
- 环烯醚萜 (135)
- 倍半萜 (397)
- 中药对照品 (1697)
- 其它酚类 (569)
- 三萜 (505)
- 荧光定量试剂盒 (2096)
- 细胞库 (825)
- 耗材和仪器 (1)
- 细胞生物学试剂 (2834)
- 进口抗体 (2254)
- ELISA Kit (2846)
- PCR基因检测试剂盒 (2216)
- 植物标准品 (1070)
- 细胞因子 (1072)
- 检测试剂盒 (4180)
- 科研抗体 (17637)
- 蛋白 (2394)
- 细胞 (918)
- 其他分类 (15)